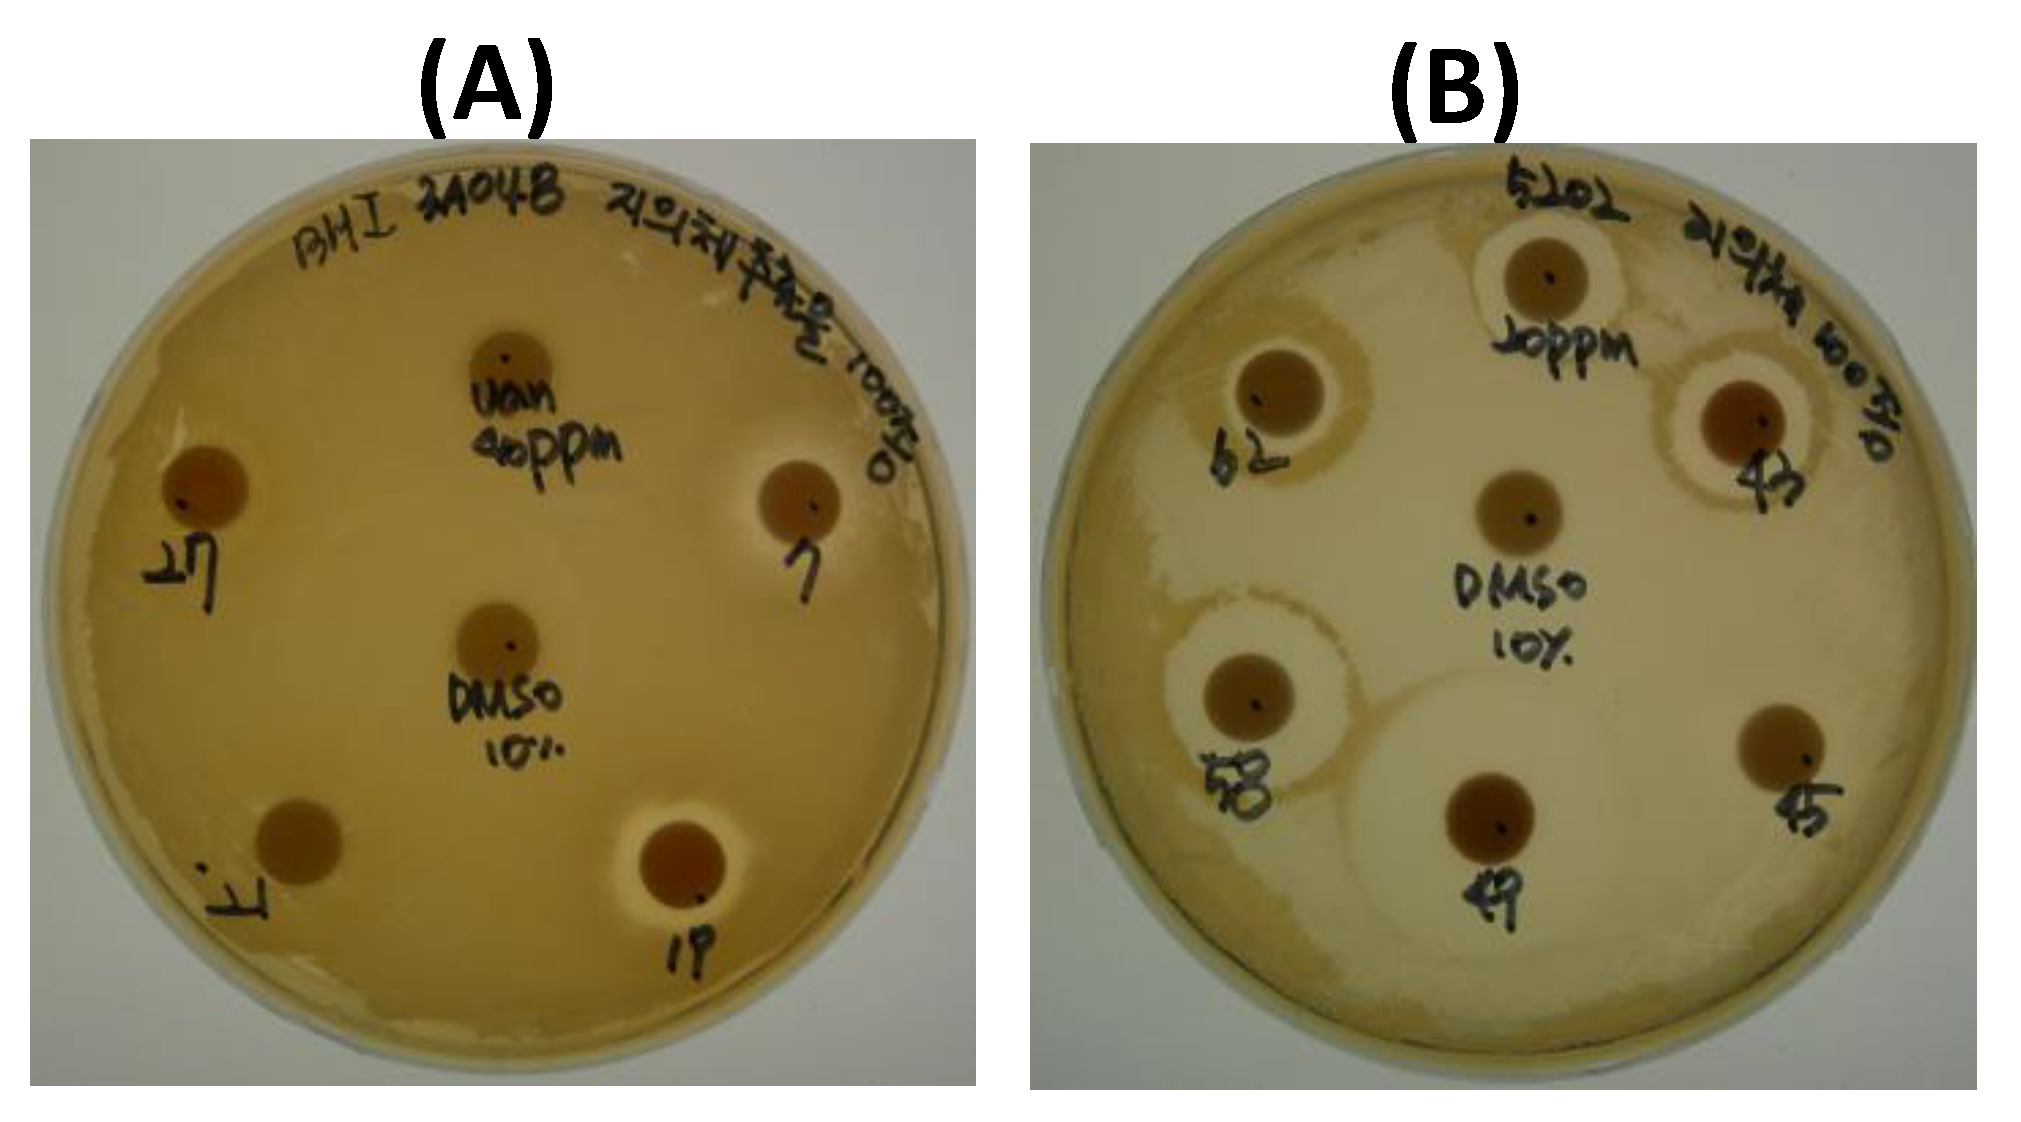
Molecules 23 03068 g001 Molecules 23 03068 g001

Antimicrobial Activity of Divaricatic Acid Isolated from the Lichen Evernia mesomorpha against Methicillin-Resistant Staphylococcus aureus
Abstract
1. Introduction
2. Results and Discussion
2.1. Antimicrobial Activity
2.1.1. Screening
2.1.2. Assay of Antimicrobial Activity
2.2. HPLC of the Selected Extracts
2.3. Structural Analysis of the Major Active Compound in E. mesomorpha
2.4. MIC
3. Materials and Methods
3.1. Chemicals and Media
3.2. Extracts of Lichen and Lichen-Forming Fungus Cultures
3.3. Microbial Strains
3.4. Antibacterial Activity Assay
3.5. Analysis of Compounds in Extracts
3.6. Isolation and Purification of Active Compounds and Structure Analysis
3.7. Minimum Inhibitory Concentration (MIC)
4. Conclusions
Supplementary Materials
Author Contributions
Funding
Acknowledgments
Conflicts of Interest
References
- Ahmadjian, V. Lichens. Annu. Rev. Microbiol. 1965, 19, 1–20. [Google Scholar] [CrossRef] [PubMed]
- Ranković, B.; Kosanić, M. Lichens as a potential source of bioactive secondary metabolites. In Lichen Secondary Metabolites; Ranković, B., Ed.; Springer: Cham, Switzerland, 2015; pp. 1–26. [Google Scholar]
- Huneck, S. The significance of lichens and their metabolites. Naturwissenschaften 1999, 86, 559–570. [Google Scholar] [CrossRef] [PubMed]
- Müller, K. Pharmaceutically relevant metabolites from lichens. Appl. Microbiol. Biotechnol. 2001, 56, 9–16. [Google Scholar] [CrossRef] [PubMed]
- Zambare, V.P.; Christopher, L.P. Biopharmaceutical potential of lichens. Pharm. Biol. 2012, 50, 778–798. [Google Scholar] [CrossRef] [PubMed]
- Ingólfsdóttir, K. Usnic acid. Phytochemistry 2002, 61, 729–736. [Google Scholar] [CrossRef]
- Cocchietto, M.; Skert, N.; Nimis, P.L.; Sava, G. A review on usnic acid, an interesting natural compound. Naturwissenschaften 2002, 89, 137–146. [Google Scholar] [CrossRef] [PubMed]
- Cansaran, D.; Kahya, D.; Yurdakulola, E.; Atakol, O. Identification and quantitation of usnic acid from the lichen Usnea species of Anatolia and antimicrobial activity. Z. Naturforsch. C 2006, 61, 773–776. [Google Scholar] [CrossRef] [PubMed]
- Victor, K.; Boris, L.; Athina, G.; Anthi, P.; Marija, S.; Marina, K.; Oliver, R.; Marina, S. Design, synthesis and antimicrobial activity of usnic acid derivatives. MedChemComm 2018, 9, 870–882. [Google Scholar] [CrossRef] [PubMed]
- Dong, J.; Qiu, J.; Wang, J.; Li, H.; Dai, X.; Zhang, Y.; Wang, X.; Tan, W.; Niu, X.; Deng, X.; et al. Apigenin alleviates the symptoms of Staphylococcus aureus pneumonia by inhibiting the production of alpha-hemolysin. FEMS Microbiol. Lett. 2013, 338, 124–131. [Google Scholar] [CrossRef] [PubMed]
- Boucher, H.W.; Corey, G.R. Epidemiology of methicillin-resistant Staphylococcus aureus. Clin. Infect. Dis. 2008, 46, S344–S349. [Google Scholar] [CrossRef] [PubMed]
- Rahman, M.M.; Amin, K.B.; Rahman, S.M.M.; Khair, A.; Rahman, M.; Hossain, A.; Rahman, A.K.M.A.; Parvez, M.S.; Miura, N.; Alam, M.M. Investigation of methicillin-resistant Staphylococcus aureus among clinical isolates from humans and animals by culture methods and multiplex PCR. BMC Vet. Res. 2018, 14, 300. [Google Scholar] [CrossRef] [PubMed]
- Campanini-Salinas, J.; Andrades-Lagos, J.; Gonzalez Rocha, G.; Choquesillo-Lazarte, D.; Bollo Dragnic, S.; Faúndez, M.; Alarcón, P.; Silva, F.; Vidal, R.; Salas-Huenuleo, E.; et al. A new kind of quinonic-antibiotic useful against multidrug-resistant S. aureus and E. faecium infections. Molecules 2018, 23, 1776. [Google Scholar] [CrossRef] [PubMed]
- Su, J.C.; Huang, Y.T.; Chen, C.S.; Chiu, H.C.; Shiau, C.W. Design and synthesis of malonamide derivatives as antibiotics against methicillin-resistant Staphylococcus aureus. Molecules 2018, 23, 27. [Google Scholar] [CrossRef] [PubMed]
- Foster, T.J. Antibiotic resistance in Staphylococcus aureus. Current status and future prospects. FEMS Microbiol. Rev. 2017, 41, 430–449. [Google Scholar] [CrossRef] [PubMed]
- Sorrell, T.C.; Packham, D.R.; Shanker, S.; Foldes, M.; Munro, R. Vancomycin therapy for methicillin-resistant Staphylococcus aureus. Ann. Intern. Med. 1982, 97, 344–350. [Google Scholar] [CrossRef] [PubMed]
- Ellison, M.J. Vancomycin, metronidazole, and tetracyclines. Clin. Podiatr. Med. Surg. 1992, 9, 425–442. [Google Scholar] [PubMed]
- Amyes, S.G. Enterococci and streptococci. Int. J. Antimicrob. Agents 2007, 29, S43–S52. [Google Scholar] [CrossRef]
- Arias, C.A.; Murray, B.E. The rise of the Enterococcus: Beyond vancomycin resistance. Nat. Rev. Microbiol. 2012, 10, 266–278. [Google Scholar] [CrossRef] [PubMed]
- González, A.G.; Barrera, J.B.; Pérez, E.M.; Padrón, C.E. Chemical Constituents of the lichen Ramalina hierrensis. Planta Med. 1992, 58, 214–218. [Google Scholar] [CrossRef] [PubMed]
- Bjerke, J.W.; Lerfall, K.; Elvebakk, A. Effects of ultraviolet radiation and PAR on the content of usnic and divaricatic acids in two arctic-alpine lichens. Photochem. Photobiol. Sci. 2002, 1, 678–685. [Google Scholar] [CrossRef] [PubMed]
- Lendemer, J.C. A taxonomic revision of the North American species of Lepraria s.l. that produce divaricatic acid, with notes on the type species of the genus L. incana. Mycologia 2011, 103, 1216–1229. [Google Scholar] [CrossRef] [PubMed]
- Brakni, R.; Ahmed, M.A.; Burger, P.; Schwing, A.; Michel, G.; Pomares, C.; Hasseine, L.; Boyer, L.; Fernandez, X.; Landreau, A.; et al. UHPLC-HRMS/MS based profiling of Algerian lichens and their antimicrobial activities. Chem. Biodivers. 2018, 15, e1800031. [Google Scholar] [CrossRef] [PubMed]
- Silva, H.A.M.F.; Siqueira, W.N.; Sá, J.L.F.; Silva, L.R.S.; Martins, M.C.B.; Aires, A.L.; Amâncio, F.F.; Pereira, E.C.; Albuquerque, M.C.P.A.; Melo, A.M.M.A.; et al. Laboratory assessment of divaricatic acid against Biomphalaria glabrata and Schistosoma mansoni cercariae. Acta Trop. 2018, 178, 97–102. [Google Scholar] [CrossRef] [PubMed]
- Marijana, K.; Branislav, R.; Slobodan, S. Antimicrobial activity of the lichen Lecanora frustulosa and Parmeliopsis hyperopta and their divaricatic acid and zeorin constituents. Afr. J. Microbiol. Res. 2010, 4, 885–890. [Google Scholar]
- Türk, H.; Yilmaz, M.; Tay, T.; Türk, A.O.; Kivanç, M. Antimicrobial activity of extracts of chemical races of the lichen Pseudevernia furfuracea and their physodic acid, chloroatranorin, atranorin, and olivetoric acid constituents. Z. Naturforsch. C 2006, 61, 499–507. [Google Scholar] [CrossRef] [PubMed]
- Sultana, N.; Afolayan, A.J. A new depsidone and antibacterial activities of compounds from Usnea undulata Stirton. J. Asian Nat. Prod. Res. 2011, 13, 1158–1164. [Google Scholar] [CrossRef] [PubMed]
- Huneck, S.; Yoshimura, I. Identification of lichen substances. In Identification of Lichen Substances; Springer: Berlin, Germany, 1996; pp. 11–123. [Google Scholar]
- Ku, T.S.; Palanisamy, S.K.; Lee, S.A. Susceptibility of Candida albicans biofilms to azithromycin, tigecycline and vancomycin and the interaction between tigecycline and antifungals. Int. J. Antimicrob. Agents 2010, 36, 441–446. [Google Scholar] [CrossRef] [PubMed]
- Maciąg-Dorszyńska, M.; Węgrzyn, G.; Guzow-Krzemińska, B. Antibacterial activity of lichen secondary metabolite usnic acid is primarily caused by inhibition of RNA and DNA synthesis. FEMS Microbiol. Lett. 2014, 353, 57–62. [Google Scholar] [CrossRef] [PubMed]
- Bellio, P.; Di Pietro, L.; Mancini, A.; Piovano, M.; Nicoletti, M.; Brisdelli, F.; Tondi, D.; Cendron, L.; Franceschini, N.; Amicosante, G.; et al. SOS response in bacteria: Inhibitory activity of lichen secondary metabolites against Escherichia coli RecA protein. Phytomedicine 2017, 29, 11–18. [Google Scholar] [CrossRef] [PubMed]
- Nguyen, K.H.; Chollet-Krugler, M.; Gouault, N.; Tomasi, S. UV-protectant metabolites from lichens and their symbiotic partners. Nat. Prod. Rep. 2013, 30, 1490–1508. [Google Scholar] [CrossRef] [PubMed]
- Luo, H.; Yamamoto, Y.; Jeon, H.S.; Liu, Y.P.; Jung, J.S.; Koh, Y.J.; Hur, J.S. Production of anti-Helicobacter pylori metabolite by the lichen-forming fungus Nephromopsis pallescens. J. Microbiol. 2011, 49, 66–70. [Google Scholar] [CrossRef] [PubMed]
- Luo, H.; Yamamota, Y.; Kim, J.A.; Jung, J.S.; Koh, Y.J.; Hur, J.S. Lecanoric acid, a secondary lichen substance with antioxidant properties from Umbilicaria antarctica in maritime Antarctica (King George Island). Polar Biol. 2009, 32, 1033–1040. [Google Scholar] [CrossRef]
- Culberson, C.F. Improved conditions and new data for the identification of lichen products by a standardized thin-layer chromatographic method. J. Chromatogr. 1972, 72, 113–125. [Google Scholar] [CrossRef]
Sample Availability: Samples of the compounds are available from the authors. |

| Sample No. | Lichen Name | S. aureus (3A048) | E. faecium (5202) |
|---|---|---|---|
| 403 | Lobaria sp. | - | 9.0 ± 1.41 |
| 407 | Usnea sp. | 11.8 ± 0.35 | 23.0 ± 1.41 |
| 412 | Everniastrum sp. | - | 13.0 ± 1.41 |
| 419 | Everniastrum sp. | 12.0 ± 2.83 | 14.5 ± 0.71 |
| 421 | . | - | 11.8 ± 0.35 |
| 422 | . | - | 12.0 ± 2.83 |
| 431 | Rhizoplaca chrysoleuca | 11.8 ± 0.35 | - |
| 433 | Evernia divaricata | - | 13.0 ± 1.41 |
| 435 | Allocetraria ambigua | - | 9.8 ± 0.35 |
| 442 | Everniastrum nepalense | - | 10.5 ± 0.71 |
| 443 | Flavocetraria cucullata | - | 12.5 ± 0.71 |
| 445 | Thamnolia vermicularis | - | 11.0 ± 1.41 |
| 449 | Rhizoplaca chrysoleuca | 10.0 ± 0.00 | 23.8 ± 0.35 |
| 458 | Evernia mesomorpha | 9.0 ± 0.50 | 17.0 ± 1.41 |
| 462 | Ramalina sp. | - | 9.8 ± 0.35 |
| 466 | Usnea sp. | 9.5 ± 0.72 | 16.0 ± 2.83 |
| 470 | Ramalina sp. | - | 15.0 ± 1.41 |
| 471 | Usnea sp. | - | 15.0 ± 1.41 |
| 472 | Usnea sp. | - | 15.0 ± 1.41 |
| 473 | Niebla ceruchoides | - | 10.3 ± 0.35 |
| 493 | Ramalina sp. | - | 14.5 ± 0.71 |
| 504 | Cladonia sp. | - | 10.5 ± 0.71 |
| 511 | Usnea articulata | - | 12.5 ± 0.71 |
| 514 | Parmotrema sp. | - | 15.0 ± 2.83 |
| 517 | Ramalina sp. | 9.0 ± 0.50 | 17.0 ± 1.41 |
| 518 | Ramalina sp. | - | 16.3 ± 0.35 |
| 519 | Usnea cf. scabrida | 10.3 ± 0.35 | 14.5 ± 0.71 |
| 523 | Usnea sp. | 9.75 ± 0.35 | 13.5 ± 0.71 |
| 535 | Heterodermia sp. | - | 11.5 ± 0.71 |
| No. | Lichen Name | Country | HPLC |
|---|---|---|---|
| 412 | Everniastrum sp. | Vietnam | Galbinic acid, Atranorin, Chloroatranorin |
| 419 | Everniastrum sp. | Vietnam | Galbinic acid, Atranorin, Chloroatranorin |
| 421 | . | China | Unknown, Usnic acid |
| 422 | . | China | Galbinic acid, Usnic acid |
| 435 | Allocetraria ambigua | China | Usnic acid |
| 442 | Everniastrum nepalense | China | Galbinic acid, Usnic acid |
| 458 | Evernia mesomorpha | China | Unknown, Divaricatic acid, Usnic acid |
| 473 | Niebla ceruchoides | Chile | Usnic acid |
| Strains | Divaricatic Acid | Vancomycin | Cefotaxime | |
|---|---|---|---|---|
| (μg/mL) | (μg/mL) | (μg/mL) | ||
| Bacillus subtilis | Gram + | 7.0 ± 2.0 | 0.78 ± 0.0 | 0.5 ± 0.0 |
| Micrococcus luteus | 40.0 ± 16.0 | 25.0 ± 0.0 | 1.0 ± 0.0 | |
| Staphylococcus epidermidis | 16.0 ± 0.0 | 25.0 ± 0.0 | 0.5 ± 0.0 | |
| Streptococcus mutans | 32.0 ± 0.0 | 12.5 ± 0.0 | 0.5 ± 0.0 | |
| Staphylococcus aureus (0027) | 64.0 ± 0.0 | 25.0 ± 0.0 | 64.0 ± 0.0 | |
| Enterococcus faecium (5202) | 16.0 ± 0.0 | 25.0 ± 0.0 | >256.0 | |
| Escherichia coli | Gram – | >256.0 | >100.0 | 0.5 ± 0 |
| Pseudomonas aeruginosa | 128.0 ± 0.0 | 31.25 ± 12.5 | 32.0 ± 0 | |
| Klebsiella pneumoniae | >256.0 | >100.0 | >100.0 | |
| Salmonella typhimurium | >256.0 | >100.0 | 0.5 ± 0 | |
| Vibrio vulnificus | >256.0 | >100.0 | 8.0 ± 0 | |
| Candida albicans | Fungus | 20.0 ± 8.0 | >100.0 | >256.0 |
| Staphylococcus aureus (3A048) | MRSA | 32.0 ± 0.0 | 25.0 ± 0.0 | >256.0 |
© 2018 by the authors. Licensee MDPI, Basel, Switzerland. This article is an open access article distributed under the terms and conditions of the Creative Commons Attribution (CC BY) license (http://creativecommons.org/licenses/by/4.0/).
Share and Cite
Oh, J.M.; Kim, Y.J.; Gang, H.-S.; Han, J.; Ha, H.-H.; Kim, H. Antimicrobial Activity of Divaricatic Acid Isolated from the Lichen Evernia mesomorpha against Methicillin-Resistant Staphylococcus aureus. Molecules 2018, 23, 3068. https://doi.org/10.3390/molecules23123068
Oh JM, Kim YJ, Gang H-S, Han J, Ha H-H, Kim H. Antimicrobial Activity of Divaricatic Acid Isolated from the Lichen Evernia mesomorpha against Methicillin-Resistant Staphylococcus aureus. Molecules. 2018; 23(12):3068. https://doi.org/10.3390/molecules23123068
Chicago/Turabian StyleOh, Jong Min, Yi Jeong Kim, Hyo-Seung Gang, Jin Han, Hyung-Ho Ha, and Hoon Kim. 2018. "Antimicrobial Activity of Divaricatic Acid Isolated from the Lichen Evernia mesomorpha against Methicillin-Resistant Staphylococcus aureus" Molecules 23, no. 12: 3068. https://doi.org/10.3390/molecules23123068
APA StyleOh, J. M., Kim, Y. J., Gang, H.-S., Han, J., Ha, H.-H., & Kim, H. (2018). Antimicrobial Activity of Divaricatic Acid Isolated from the Lichen Evernia mesomorpha against Methicillin-Resistant Staphylococcus aureus. Molecules, 23(12), 3068. https://doi.org/10.3390/molecules23123068

